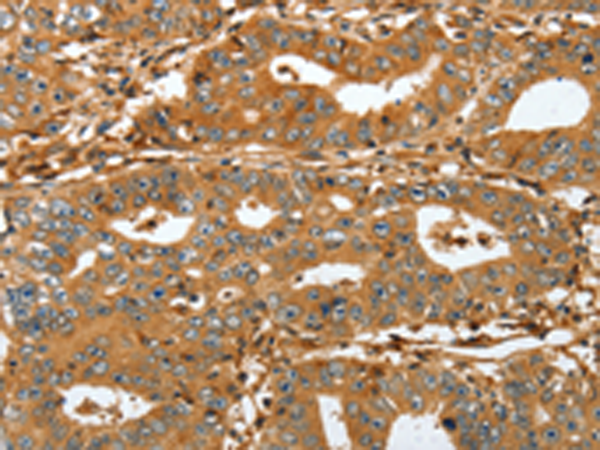
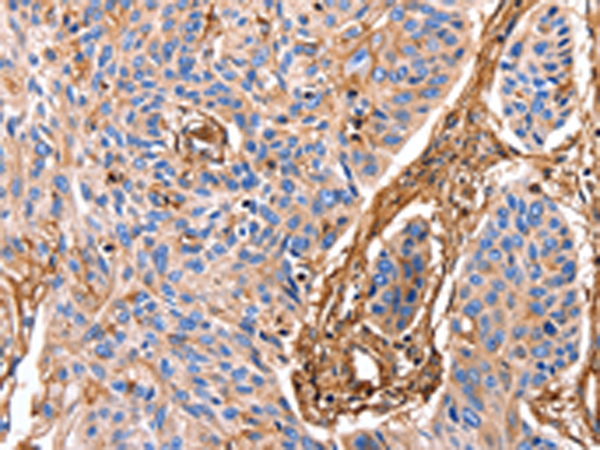

-
分类: 科研抗体货号: P07088别名: PC; K17; PC2; 39.1; CK-17; PCHC1应用: IHC反应种属: Human, Mouse, Rat
-
分类: 科研抗体货号: P07087别名: K8; KO; CK8; CK-8; CYK8; K2C8; CARD2应用: IHC反应种属: Human, Mouse, Rat
-
分类: 科研抗体货号: P07110别名:应用: WB,IHC反应种属: Human
-
分类: 科研抗体货号: P07086别名: K18; CYK18应用: WB,IHC反应种属: Human, Mouse, Rat
-
分类: 科研抗体货号: P07130别名: FP497应用: WB,IHC反应种属: Human
-
分类: 科研抗体货号: P07108别名: RAP1; C21KG; G-22K; KREV1; KREV-1; SMGP21应用: WB,IHC反应种属: Human, Mouse, Rat
-
分类: 科研抗体货号: P07085别名: ISA; ANX13应用: WB,IHC反应种属: Human, Mouse, Rat
-
分类: 科研抗体货号: P07129别名: FHF1, FGF12B应用: WB反应种属: Human, Mouse, Rat
-
分类: 科研抗体货号: P07107别名: ANDD; CMRD; GTBPB; SARA2应用: IHC反应种属: Human, Mouse, Rat
-
分类: 科研抗体货号: P07083别名: ANX6, CBP68应用: WB,IHC反应种属: Human, Mouse, Rat

鄂公网安备42018502007531号
鄂公网安备42018502007531号

